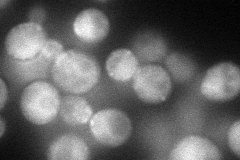
YPL204W
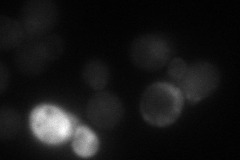
YPL204W
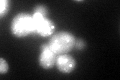
YPL204W
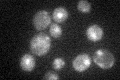
YPL204W
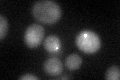
YPL204W

View description
Protein kinase involved in regulating diverse events including vesicular trafficking, DNA repair, and chromosome segregation; binds the CTD of RNA pol II; homolog of mammalian casein kinase 1delta (CK1delta)
Localization:
Intensity:
Fold change:
Significance:
-
C’ GFP library in SD

nucleus, cytosol65 -
N' NOP1pr-GFP in SD
cytosol,bud neck77.4959 -
N' TEF2pr-mCherry in SD
punctate,bud neck30.084 -
N' NATIVEpr-GFP in SD

cytosol,bud neck68.7478 -
N' TEF2pr-VC and Cyto-VN in SD

below threshold27.0242 -
C’ GFP library in SD+DTT
nucleus, cytosol77.741.19No -
C’ GFP library in SD+H2O2

nucleus, cytosol61.890.95No -
C’ GFP library in Starvation Media
nucleus, cytosol44.990.69No -
C’ GFP library on the background of Pup2-DaMP
punctate -
C’ GFP library on the background of CCT mutant

nucleus, cytosol59.48050.914893No
